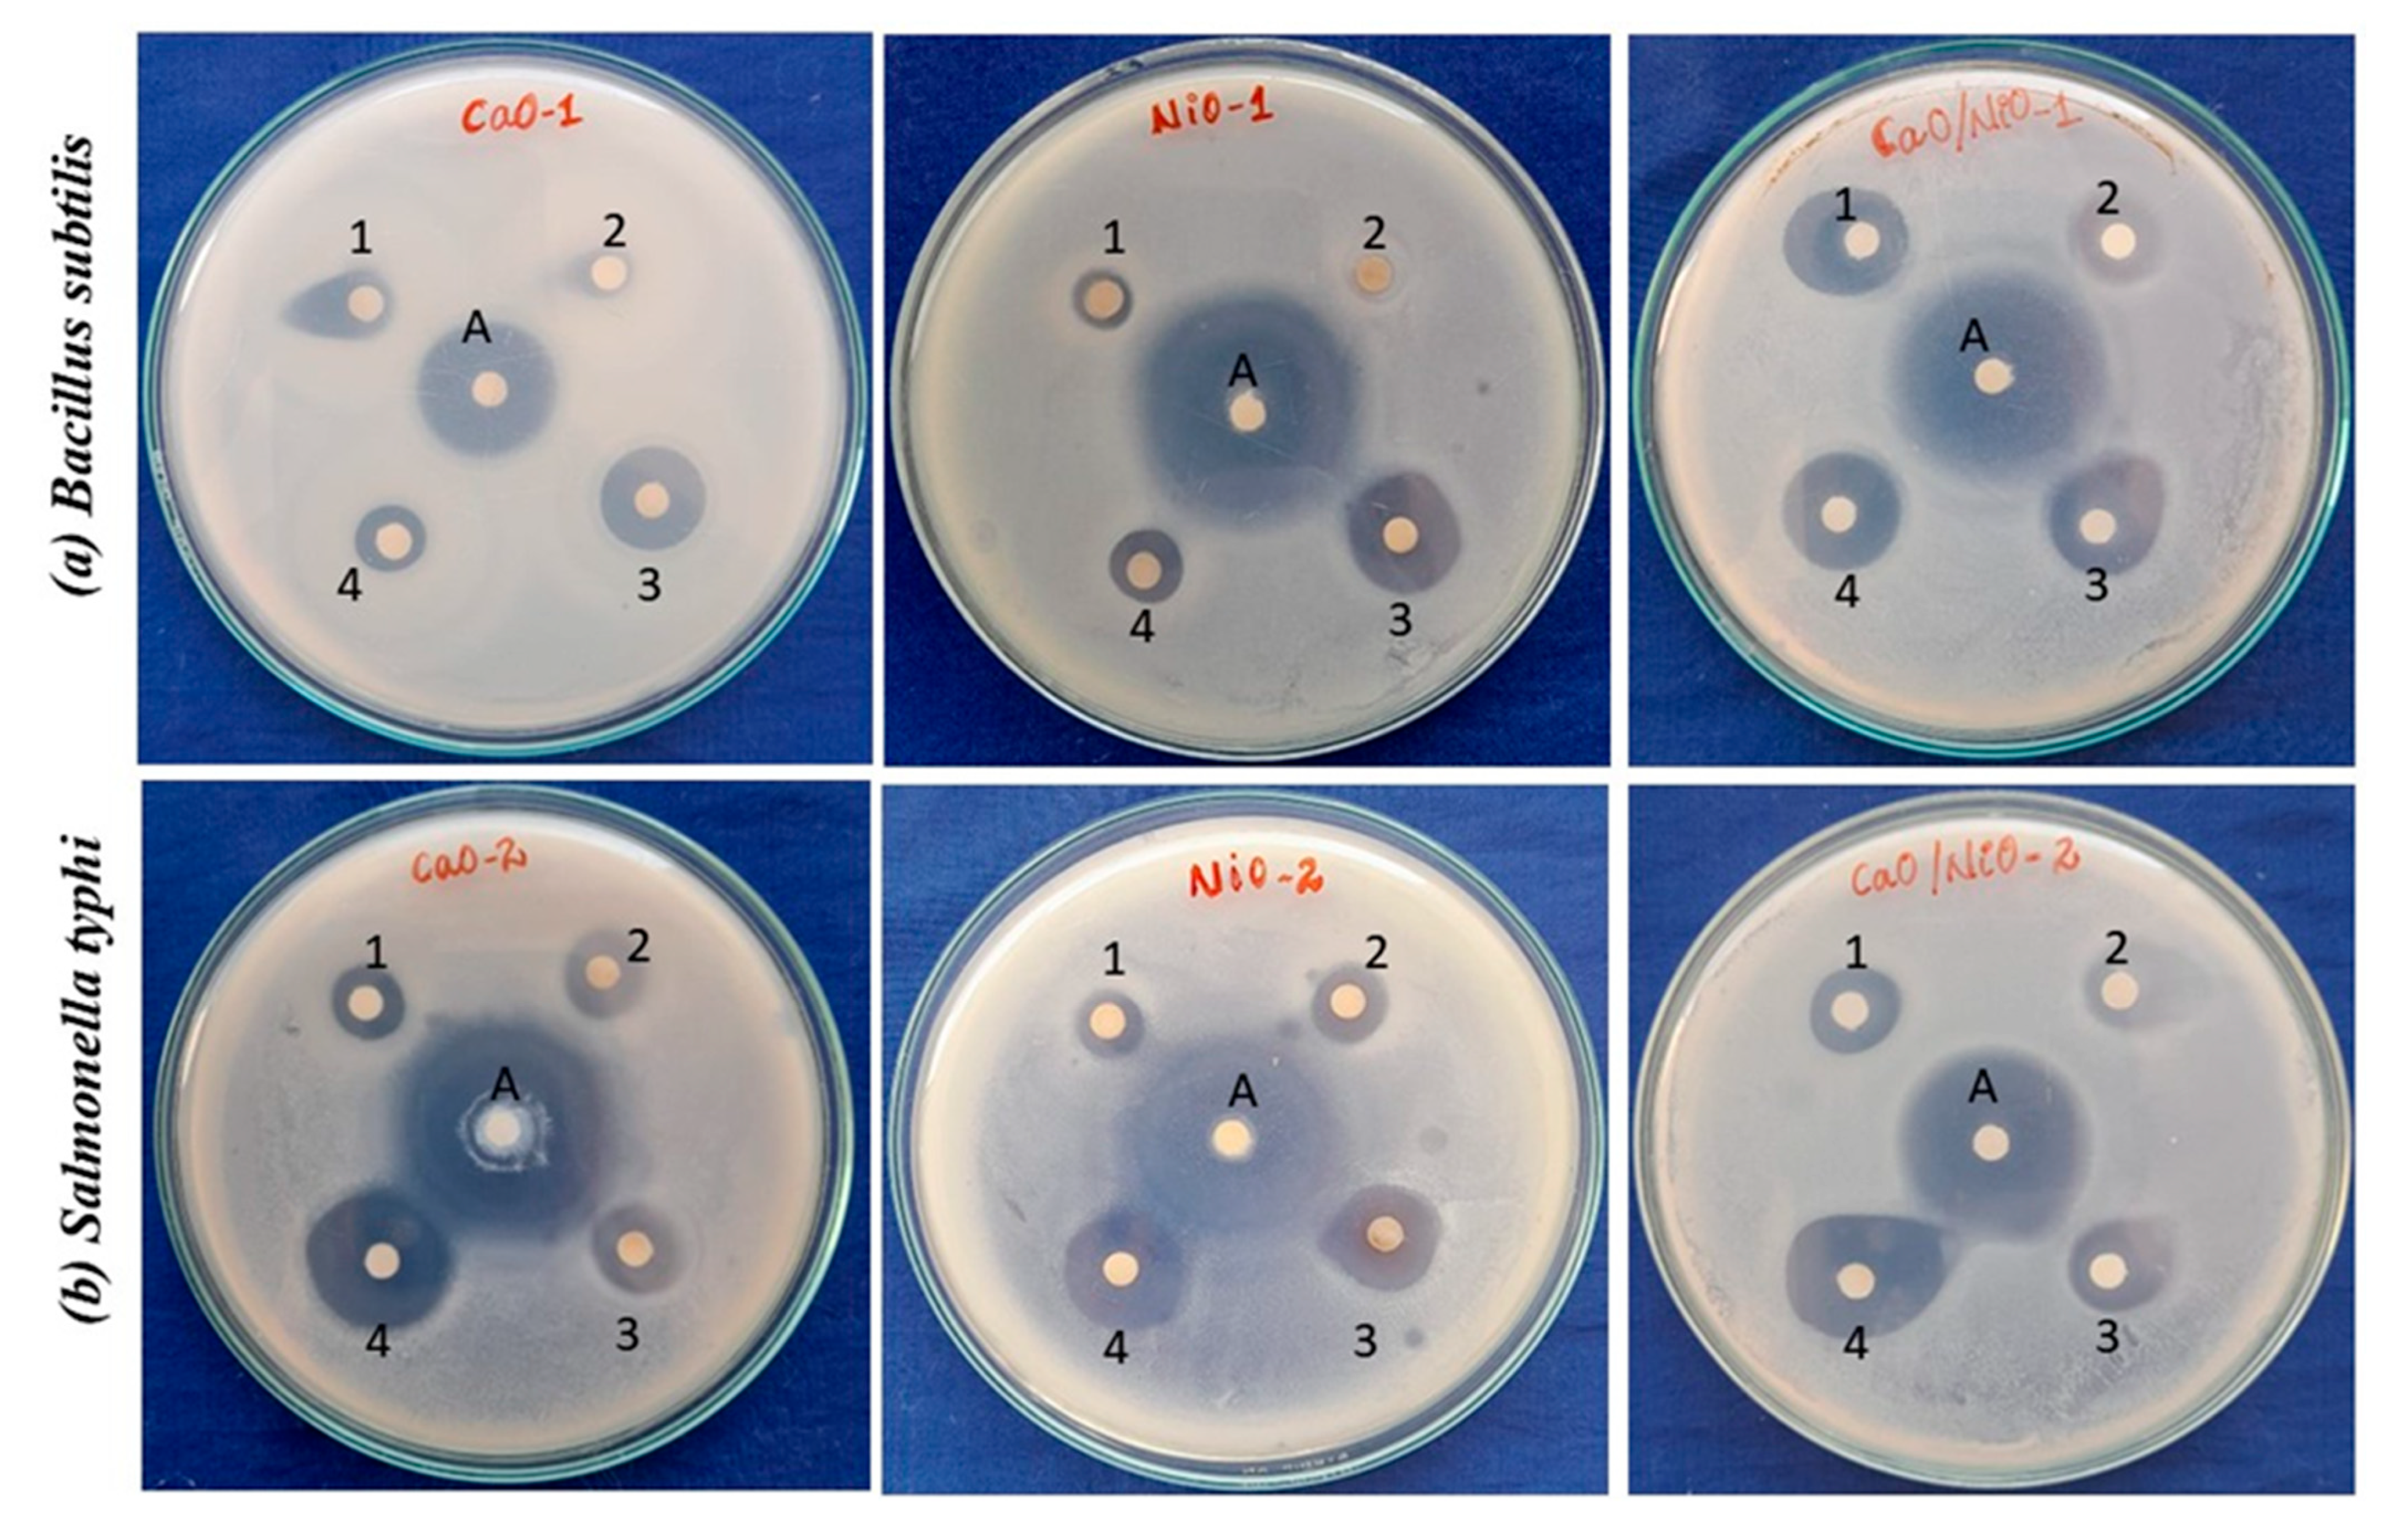

Sustainable Biogenic Synthesis of High-Performance CaO/NiO Nanocomposite for Antimicrobial, Antioxidant, and Antidiabetic Applications
Abstract
1. Introduction
2. Experimental Methods
2.1. Synthesis of CaO, NiO, and CaO/NiO Samples
2.2. Characterization Techniques
2.3. Biological Activity Assessment
2.3.1. Antimicrobial Activity by Disc Diffusion Method
2.3.2. Minimum Inhibitory Concentration (MIC)
2.3.3. Antioxidant Activity by DPPH Radical Scavenging Activity
2.3.4. Antioxidant Activity by Superoxide Anion Radical Scavenging
2.3.5. Antidiabetic Activity by α-Amylase Inhibitory Assay
2.3.6. Antidiabetic Activity by α-Glucosidase Inhibitory Assay
2.4. Statistical Analysis
3. Results and Discussion
3.1. XRD Analysis
3.2. Functional Group Analysis
3.3. UV–Visible Diffuse Reflectance Studies
3.4. Morphological Analysis
3.5. XPS Analysis
3.6. Antibacterial Assessment
3.7. Antioxidant Activity
3.8. Antidiabetic Activity
4. Conclusions
Author Contributions
Funding
Institutional Review Board Statement
Informed Consent Statement
Data Availability Statement
Acknowledgments
Conflicts of Interest
References
- Sierra-Vargas, M.P.; Montero-Vargas, J.M.; Debray-García, Y.; Vizuet-de-Rueda, J.C.; Loaeza-Román, A.; Terán, L.M. Oxidative Stress and Air Pollution: Its Impact on Chronic Respiratory Diseases. Int. J. Mol. Sci. 2023, 24, 853. [Google Scholar] [CrossRef] [PubMed]
- Leni, Z.; Künzi, L.; Geiser, M. Air Pollution Causing Oxidative Stress. Curr. Opin. Toxicol. 2020, 20–21, 1–8. [Google Scholar] [CrossRef]
- Hu, X.; Zhang, Y.; Ding, T.; Liu, J.; Zhao, H. Multifunctional Gold Nanoparticles: A Novel Nanomaterial for Various Medical Applications and Biological Activities. Front. Bioeng. Biotechnol. 2020, 8, 990. [Google Scholar] [CrossRef] [PubMed]
- Samad, N.; Ejaz, U.; Kousar, S.; Al-Mutairi, A.A.; Khalid, A.; Amin, Z.S.; Bashir, S.; Al-Hussain, S.A.; Irfan, A.; Zaki, M.E.A. A Novel Approach to Assessing the Antioxidant and Anti-Diabetic Potential of Synthesized Calcium Carbonate Nanoparticles Using Various Extracts of Ailanthus Altissima. Front. Chem. 2024, 12, 1345950. [Google Scholar] [CrossRef]
- Mazher, M.; Ishtiaq, M.; Hamid, B.; Haq, S.M.; Mazhar, A.; Bashir, F.; Mazhar, M.; Mahmoud, E.A.; Casini, R.; Alataway, A.; et al. Biosynthesis and Characterization of Calcium Oxide Nanoparticles from Citrullus Colocynthis Fruit Extracts; Their Biocompatibility and Bioactivities. Materials 2023, 16, 2768. [Google Scholar] [CrossRef]
- Dai, Y.; Guo, Y.; Tang, W.; Chen, D.; Xue, L.; Chen, Y.; Guo, Y.; Wei, S.; Wu, M.; Dai, J.; et al. Reactive Oxygen Species-Scavenging Nanomaterials for the Prevention and Treatment of Age-Related Diseases. J. Nanobiotechnol. 2024, 22, 252. [Google Scholar] [CrossRef]
- Foulkes, R.; Man, E.; Thind, J.; Yeung, S.; Joy, A.; Hoskins, C. The Regulation of Nanomaterials and Nanomedicines for Clinical Application: Current and Future Perspectives. Biomater. Sci. 2020, 8, 4653–4664. [Google Scholar] [CrossRef]
- Vallejo Castaño, S.; Callagon La Plante, E.; Shimoda, S.; Wang, B.; Neithalath, N.; Sant, G.; Pilon, L. Calcination-Free Production of Calcium Hydroxide at Sub-Boiling Temperatures. RSC Adv. 2021, 11, 1762–1772. [Google Scholar] [CrossRef]
- Anbu, P.; Gopinath, S.C.B.; Saravanakumar, K.; Vijayakumar, S.; Ramanathan, S.; Wang, M.-H. Bimetallic Mixed Metal Oxide (CuO/NiO) in Fusion with Nitrogen-Doped Graphene Oxide: An Alternate Approach for Developing Potential Biocarrier. J. Environ. Chem. Eng. 2021, 9, 105781. [Google Scholar] [CrossRef]
- Singh, H.; Desimone, M.F.; Pandya, S.; Jasani, S.; George, N.; Adnan, M.; Aldarhami, A.; Bazaid, A.S.; Alderhami, S.A. Revisiting the Green Synthesis of Nanoparticles: Uncovering Influences of Plant Extracts as Reducing Agents for Enhanced Synthesis Efficiency and Its Biomedical Applications. Int. J. Nanomed. 2023, 18, 4727–4750. [Google Scholar] [CrossRef]
- Szczyglewska, P.; Feliczak-Guzik, A.; Nowak, I. Nanotechnology–General Aspects: A Chemical Reduction Approach to the Synthesis of Nanoparticles. Molecules 2023, 28, 4932. [Google Scholar] [CrossRef] [PubMed]
- Rashad, A.M. A Concise on the Effect of Calcium Oxide on the Properties of Alkali-Activated Materials: A Manual for Civil Engineers. Int. J. Concr. Struct. Mater. 2023, 17, 72. [Google Scholar] [CrossRef]
- Niu, Y.-Q.; Liu, J.-H.; Aymonier, C.; Fermani, S.; Kralj, D.; Falini, G.; Zhou, C.-H. Calcium Carbonate: Controlled Synthesis, Surface Functionalization, and Nanostructured Materials. Chem. Soc. Rev. 2022, 51, 7883–7943. [Google Scholar] [CrossRef] [PubMed]
- Jimoh, O.A.; Ariffin, K.S.; Hussin, H.B.; Temitope, A.E. Synthesis of Precipitated Calcium Carbonate: A Review. Carbonates Evaporites 2018, 33, 331–346. [Google Scholar] [CrossRef]
- Vallejo Castaño, S.; Callagon La Plante, E.; Shimoda, S.; Wang, B.; Neithalath, N.; Sant, G.; Pilon, L. Calcination-Free Production of Calcium Hydroxide at Sub-Boiling Temperatures. RSC Adv. 2021, 11, 1762–1772. [Google Scholar] [CrossRef]
- Sinha, T.; Ahmaruzzaman, M.; Adhikari, P.P.; Bora, R. Green and Environmentally Sustainable Fabrication of Ag-SnO2 Nanocomposite and Its Multifunctional Efficacy As Photocatalyst and Antibacterial and Antioxidant Agent. ACS Sustain. Chem. Eng. 2017, 5, 4645–4655. [Google Scholar] [CrossRef]
- Wang, G.; Zheng, J.; Xu, B.; Zhang, C.; Zhu, Y.; Fang, Z.; Yang, Z.; Shang, M.-H.; Yang, W. Tailored Electronic Band Gap and Valance Band Edge of Nickel Oxide via P-Type Incorporation. J. Phys. Chem. C 2021, 125, 7495–7501. [Google Scholar] [CrossRef]
- Heng, M.H.; Win, Y.F.; Cheah, E.S.G.; Chan, Y.B.; Rahman, M.K.; Sultana, S.; Tey, L.-H.; Wong, L.S.; Djearamane, S.; Akhtaruzzaman, M.; et al. Microwave-Assisted Green Synthesis, Characterization, and in Vitro Antibacterial Activity of NiO Nanoparticles Obtained from Lemon Peel Extract. Green Process. Synth. 2024, 13, 20240071. [Google Scholar] [CrossRef]
- Ben Hsouna, A.; Sadaka, C.; Generalić Mekinić, I.; Garzoli, S.; Švarc-Gajić, J.; Rodrigues, F.; Morais, S.; Moreira, M.M.; Ferreira, E.; Spigno, G.; et al. The Chemical Variability, Nutraceutical Value, and Food-Industry and Cosmetic Applications of Citrus Plants: A Critical Review. Antioxidants 2023, 12, 481. [Google Scholar] [CrossRef]
- Priyadharshini, S.; Jasmine Jecintha Kay, S.; Ayyanar, M.; Jenipher, C.; Thirumurugan, A.; Isaac, R.S.R.; Chidhambaram, N. A Cleaner and Multifunctional Citrus Limonium-Assisted ZnO/MgO Nanocomposite Synthesis: Extensive Investigations on Antibacterial, Antioxidant, and Antidiabetic Applications. Mater. Today Commun. 2024, 41, 110620. [Google Scholar] [CrossRef]
- Khan, F.U.; Khan, Z.U.H.; Ma, J.; Khan, A.U.; Sohail, M.; Chen, Y.; Yang, Y.; Pan, X. An Astragalus Membranaceus Based Eco-Friendly Biomimetic Synthesis Approach of ZnO Nanoflowers with an Excellent Antibacterial, Antioxidant and Electrochemical Sensing Effect. Mater. Sci. Eng. C 2021, 118, 111432. [Google Scholar] [CrossRef] [PubMed]
- Darwish, R.M.; Salama, A.H. Study the Effect of Conjugate Novel Ultra-Short Antimicrobial Peptide with Silver Nanoparticles against Methicillin Resistant S. aureus and ESBL E. coli. Antibiotics 2022, 11, 1024. [Google Scholar] [CrossRef] [PubMed]
- Hosny, M.; Fawzy, M.; Abdelfatah, A.M.; Fawzy, E.E.; Eltaweil, A.S. Comparative Study on the Potentialities of Two Halophytic Species in the Green Synthesis of Gold Nanoparticles and Their Anticancer, Antioxidant and Catalytic Efficiencies. Adv. Powder Technol. 2021, 32, 3220–3233. [Google Scholar] [CrossRef]
- Hazekawa, M.; Nishinakagawa, T.; Kawakubo-Yasukochi, T.; Nakashima, M. Evaluation of IC50 Levels Immediately after Treatment with Anticancer Reagents Using a Real-time Cell Monitoring Device. Exp. Ther. Med. 2019. [Google Scholar] [CrossRef]
- Noreen, H.; Semmar, N.; Farman, M.; McCullagh, J.S.O. Measurement of Total Phenolic Content and Antioxidant Activity of Aerial Parts of Medicinal Plant Coronopus Didymus. Asian Pac. J. Trop. Med. 2017, 10, 792–801. [Google Scholar] [CrossRef]
- Amalraj, S.; Krupa, J.; Sriramavaratharajan, V.; Mariyammal, V.; Murugan, R.; Ayyanar, M. Chemical Characterization, Antioxidant, Antibacterial and Enzyme Inhibitory Properties of Canthium Coromandelicum, a Valuable Source for Bioactive Compounds. J. Pharm. Biomed. Anal. 2021, 192, 113620. [Google Scholar] [CrossRef]
- Karthick, V.; Zahir, A.A.; Ayyanar, M.; Amalraj, S.; Anbarasan, K.; Rahuman, A.A.; Kadaikunnan, S.; Kamaraj, C.; Thiruvengadam, M.; Gangapriya, P.; et al. Optimization and Characterization of Eco-Friendly Formulated ZnO NPs in Various Parameters: Assessment of Its Antidiabetic, Antioxidant and Antibacterial Properties. Biomass Convers. Biorefin 2024, 14, 24567–24581. [Google Scholar] [CrossRef]
- Shirsath, S.R.; Bhanvase, B.A.; Sonawane, S.H.; Gogate, P.R.; Pandit, A.B. A Novel Approach for Continuous Synthesis of Calcium Carbonate Using Sequential Operation of Two Sonochemical Reactors. Ultrason. Sonochem 2017, 35, 124–133. [Google Scholar] [CrossRef]
- Amal, R.; Nadeem, R.; Intisar, A.; Rouf, H.; Hussain, D.; Kousar, R. An Insight into the Catalytic Properties and Process Optimization of Fe, Ni Doped Eggshell Derived CaO for a Green Biodiesel Synthesis from Waste Chicken Fat. Catal. Commun. 2024, 187, 106848. [Google Scholar] [CrossRef]
- Amir, A.; Bibi, S.; Nawaz, A.; Ibrahim, A.; Ashiq, M.N.; Saeed, M.Q.; Hamza, M.; Rasheed, H.M.Z.; Islam, B. In Vitro Antibacterial Response of ZnO-MgO Nanocomposites at Various Compositions. Int. J. Appl. Ceram. Technol. 2021, 18, 1417–1429. [Google Scholar] [CrossRef]
- Gupta, U.; Singh, V.K.; Kumar, V.; Khajuria, Y. Experimental and Theoretical Spectroscopic Studies of Calcium Carbonate (CaCO3). Materials Focus 2015, 4, 164–169. [Google Scholar] [CrossRef]
- Hussein, A.I.; Ab-Ghani, Z.; Che Mat, A.N.; Ab Ghani, N.A.; Husein, A.; Ab. Rahman, I. Synthesis and Characterization of Spherical Calcium Carbonate Nanoparticles Derived from Cockle Shells. Appl. Sci. 2020, 10, 7170. [Google Scholar] [CrossRef]
- Alam, M.W.; BaQais, A.; Mir, T.A.; Nahvi, I.; Zaidi, N.; Yasin, A. Effect of Mo Doping in NiO Nanoparticles for Structural Modification and Its Efficiency for Antioxidant, Antibacterial Applications. Sci. Rep. 2023, 13, 1328. [Google Scholar] [CrossRef] [PubMed]
- Minisha, S.; Johnson, J.; Mohammad Wabaidur, S.; Gupta, J.K.; Aftab, S.; Siddiqui, M.R.; Lai, W.-C. Synthesis and Characterizations of Fe-Doped NiO Nanoparticles and Their Potential Photocatalytic Dye Degradation Activities. Sustainability 2023, 15, 14552. [Google Scholar] [CrossRef]
- Agnes, J.; Selvakumar, M.S.; Prem Anand, D. Synthesis and Characterization of Chitosan Encapsulated Nickel Oxide Nanoparticles Modified with Folic Acid. Mater. Today Proc. 2022, 66, 1658–1663. [Google Scholar] [CrossRef]
- Sabouri, Z.; Akbari, A.; Hosseini, H.A.; Darroudi, M. Facile Green Synthesis of NiO Nanoparticles and Investigation of Dye Degradation and Cytotoxicity Effects. J. Mol. Struct. 2018, 1173, 931–936. [Google Scholar] [CrossRef]
- Alshatwi, M.S.; Alburaih, H.A.; Alghamdi, S.S.; Alfadhil, D.A.; Alshehri, J.A.; Aljamaan, F.A. Iron-Doped Nickel Oxide Nanoparticles Synthesis and Analyzing Different Properties. Adv. Sci. Technol. Eng. Syst. J. 2021, 6, 1422–1426. [Google Scholar] [CrossRef]
- Khodair, Z.T.; Ibrahim, N.M.; Kadhim, T.J.; Mohammad, A.M. Synthesis and Characterization of Nickel Oxide (NiO) Nanoparticles Using an Environmentally Friendly Method, and Their Biomedical Applications. Chem. Phys. Lett. 2022, 797, 139564. [Google Scholar] [CrossRef]
- Witoon, T. Characterization of Calcium Oxide Derived from Waste Eggshell and Its Application as CO2 Sorbent. Ceram. Int. 2011, 37, 3291–3298. [Google Scholar] [CrossRef]
- Vijaya Kumar, P.; Jafar Ahamed, A.; Karthikeyan, M. Synthesis and Characterization of NiO Nanoparticles by Chemical as Well as Green Routes and Their Comparisons with Respect to Cytotoxic Effect and Toxicity Studies in Microbial and MCF-7 Cancer Cell Models. SN Appl. Sci. 2019, 1, 1083. [Google Scholar] [CrossRef]
- Jadhav, V.; Bhagare, A.; Wahab, S.; Lokhande, D.; Vaidya, C.; Dhayagude, A.; Khalid, M.; Aher, J.; Mezni, A.; Dutta, M. Green Synthesized Calcium Oxide Nanoparticles (CaO NPs) Using Leaves Aqueous Extract of Moringa oleifera and Evaluation of Their Antibacterial Activities. J. Nanomater. 2022, 2022, 9047507. [Google Scholar] [CrossRef]
- Zenkin, K.; Durmuş, S.; Emre, D.; Bilici, A.; Yılmaz, S. Salvia Officinalis Leaf Extract-Stabilized NiO NPs, ZnO NPs, and NiO@ZnO Nanocomposite: Green Hydrothermal Synthesis, Characterization and Supercapacitor Application. Biomass Convers. Biorefin 2024. [Google Scholar] [CrossRef]
- El-Belely, E.F.; Farag, M.M.S.; Said, H.A.; Amin, A.S.; Azab, E.; Gobouri, A.A.; Fouda, A. Green Synthesis of Zinc Oxide Nanoparticles (ZnO-NPs) Using Arthrospira Platensis (Class: Cyanophyceae) and Evaluation of Their Biomedical Activities. Nanomaterials 2021, 11, 95. [Google Scholar] [CrossRef] [PubMed]
- Araya-Castro, K.; Chao, T.-C.; Durán-Vinet, B.; Cisternas, C.; Ciudad, G.; Rubilar, O. Green Synthesis of Copper Oxide Nanoparticles Using Protein Fractions from an Aqueous Extract of Brown Algae Macrocystis Pyrifera. Processes 2020, 9, 78. [Google Scholar] [CrossRef]
- Cabrera-Penna, M.; Rodríguez-Páez, J.E. Calcium Oxyhydroxide (CaO/Ca(OH)2) Nanoparticles: Synthesis, Characterization and Evaluation of Their Capacity to Degrade Glyphosate-Based Herbicides (GBH). Adv. Powder Technol. 2021, 32, 237–253. [Google Scholar] [CrossRef]
- Imtiaz, A.; Farrukh, M.A.; Khaleeq-ur-rahman, M.; Adnan, R. Micelle-Assisted Synthesis of Al 2 O 3 ·CaO Nanocatalyst: Optical Properties and Their Applications in Photodegradation of 2,4,6-Trinitrophenol. Sci. World J. 2013, 2013, 641420. [Google Scholar] [CrossRef]
- Panicker, N.J.; Sahu, P.P. Green Reduction of Graphene Oxide Using Phytochemicals Extracted from Pomelo Grandis and Tamarindus Indica and Its Supercapacitor Applications. J. Mater. Sci. Mater. Electron. 2021, 32, 15265–15278. [Google Scholar] [CrossRef]
- Uddin, S.; Safdar, L.B.; Anwar, S.; Iqbal, J.; Laila, S.; Abbasi, B.A.; Saif, M.S.; Ali, M.; Rehman, A.; Basit, A.; et al. Green Synthesis of Nickel Oxide Nanoparticles from Berberis Balochistanica Stem for Investigating Bioactivities. Molecules 2021, 26, 1548. [Google Scholar] [CrossRef]
- Hossain, A.; Abdallah, Y.; Ali, M.A.; Masum, M.M.I.; Li, B.; Sun, G.; Meng, Y.; Wang, Y.; An, Q. Lemon-Fruit-Based Green Synthesis of Zinc Oxide Nanoparticles and Titanium Dioxide Nanoparticles against Soft Rot Bacterial Pathogen Dickeya Dadantii. Biomolecules 2019, 9, 863. [Google Scholar] [CrossRef]
- Muhaymin, A.; Mohamed, H.E.A.; Hkiri, K.; Safdar, A.; Azizi, S.; Maaza, M. Green Synthesis of Magnesium Oxide Nanoparticles Using Hyphaene Thebaica Extract and Their Photocatalytic Activities. Sci. Rep. 2024, 14, 20135. [Google Scholar] [CrossRef]
- Nilavazhagan, S.; Anbuselvan, D.; Santhanam, A.; Chidhambaram, N. Effect of an Alkali Hydroxide Concentration on the Structural, Optical, and Surface Morphological Properties of ZnO Nanoparticles. Appl. Phys. A 2020, 126, 279. [Google Scholar] [CrossRef]
- Kay, S.J.J.; Chidhambaram, N.; Thirumurugan, A.; Shanavas, S.; Sakthivel, P.; Rimal Isaac, R.S. Stoichiometric Balancing of Bismuth Ferrite-Perovskite Nanoparticles: Comparative Investigations on Biogenic versus Conventional Chemical Synthesis. J. Mater. Sci. Mater. Electron. 2023, 34, 2034. [Google Scholar] [CrossRef]
- Suvith, V.S.; Devu, V.S.; Philip, D. Facile Synthesis of SnO2/NiO Nano-Composites: Structural, Magnetic and Catalytic Properties. Ceram. Int. 2020, 46, 786–794. [Google Scholar] [CrossRef]
- Song, L.; Zhang, S.; Chen, B.; Sun, D. Highly Active NiO–CaO Photocatalyst for Degrading Organic Contaminants under Visible-Light Irradiation. Catal. Commun. 2009, 10, 421–423. [Google Scholar] [CrossRef]
- Mathivanan, D.; Kirankumar, V.S.; Sumathi, S.; Suseem, S.R. Facile Biosynthesis of Calcium Hydroxide Nanoparticles Using Andrographis Echioides Leaf Extract and Its Photocatalytic Activity Under Different Light Source. J. Clust. Sci. 2018, 29, 167–175. [Google Scholar] [CrossRef]
- Weldekirstos, H.D.; Habtewold, B.; Kabtamu, D.M. Surfactant-Assisted Synthesis of NiO-ZnO and NiO-CuO Nanocomposites for Enhanced Photocatalytic Degradation of Methylene Blue Under UV Light Irradiation. Front. Mater. 2022, 9, 832439. [Google Scholar] [CrossRef]
- Degfie, T.A.; Mamo, T.T.; Mekonnen, Y.S. Optimized Biodiesel Production from Waste Cooking Oil (WCO) Using Calcium Oxide (CaO) Nano-Catalyst. Sci. Rep. 2019, 9, 18982. [Google Scholar] [CrossRef]
- Amin Alavi, M.; Morsali, A. Ultrasonic-Assisted Synthesis of Ca(OH) 2 and CaO Nanostructures. J. Exp. Nanosci. 2010, 5, 93–105. [Google Scholar] [CrossRef]
- Rajith Kumar, C.R.; Betageri, V.S.; Nagaraju, G.; Pujar, G.H.; Suma, B.P.; Latha, M.S. Photocatalytic, Nitrite Sensing and Antibacterial Studies of Facile Bio-Synthesized Nickel Oxide Nanoparticles. J. Sci. Adv. Mater. Devices 2020, 5, 48–55. [Google Scholar] [CrossRef]
- Basavaraju, B.; Nagaraja, S.; Banagar, A.R.; Srinivasa, C.V.; Ramesh, B.T.; Ramdan, D.; Ammarullah, M.I. Influence of Suspended Cenospheres on the Mechanical Characteristics and Wear Loss of Natural Fiber-Reinforced Hybrid Composites: Implications for Biomedical Applications and Sustainable Material Management. RSC Adv. 2024, 14, 33332–33344. [Google Scholar] [CrossRef]
- Granados, M.L.; Poves, M.D.Z.; Alonso, D.M.; Mariscal, R.; Galisteo, F.C.; Moreno-Tost, R.; Santamaría, J.; Fierro, J.L.G. Biodiesel from Sunflower Oil by Using Activated Calcium Oxide. Appl. Catal. B 2007, 73, 317–326. [Google Scholar] [CrossRef]
- Vanthana Sree, G.; Nagaraaj, P.; Kalanidhi, K.; Aswathy, C.A.; Rajasekaran, P. Calcium Oxide a Sustainable Photocatalyst Derived from Eggshell for Efficient Photo-Degradation of Organic Pollutants. J. Clean. Prod. 2020, 270, 122294. [Google Scholar] [CrossRef]
- Chatla, A.; Almanassra, I.W.; Kochkodan, V.; Laoui, T.; Alawadhi, H.; Atieh, M.A. Efficient Removal of Eriochrome Black T (EBT) Dye and Chromium (Cr) by Hydrotalcite-Derived Mg-Ca-Al Mixed Metal Oxide Composite. Catalysts 2022, 12, 1247. [Google Scholar] [CrossRef]
- Wei, X.; Chen, S.; Rong, J.; Sui, Z.; Wang, S.; Lin, Y.; Xiao, J.; Huang, D. Improving the Ca(II) Adsorption of Chitosan via Physical and Chemical Modifications and Charactering the Structures of the Calcified Complexes. Polym. Test. 2021, 98, 107192. [Google Scholar] [CrossRef]
- Kitchamsetti, N.; Ramteke, M.S.; Rondiya, S.R.; Mulani, S.R.; Patil, M.S.; Cross, R.W.; Dzade, N.Y.; Devan, R.S. DFT and Experimental Investigations on the Photocatalytic Activities of NiO Nanobelts for Removal of Organic Pollutants. J. Alloys Compd. 2021, 855, 157337. [Google Scholar] [CrossRef]
- Chen, X.; Wang, X.; Fang, D. A Review on C1s XPS-Spectra for Some Kinds of Carbon Materials. Fuller. Nanotub. Carbon Nanostruct. 2020, 28, 1048–1058. [Google Scholar] [CrossRef]
- Ramasamy, V.; Sathishpriya, T.; Thenpandiyan, E.; Suresh, G.; Sagadevan, S. Eco-Friendly Synthesis of Cadmium-Loaded CaCO3/PMMA Nanocomposite for an Enhanced Photocatalytic Activity for Removal of Organic Dyes in the Aqueous Solution. Biomass Convers. Biorefin 2025, 15, 3585–3597. [Google Scholar] [CrossRef]
- Li, N.; Luo, Z.; Zeng, C.; Chen, L.; Yang, H.; Gong, S. Antibacterial Activity and Possible Mechanisms of One-Step Synthetic Laminated Flower-like Nickelous(II) Hydroxide. SN Appl. Sci. 2019, 1, 931. [Google Scholar] [CrossRef]
- Darwish, N.; Ashani, M.; Lewis, I.A.; Husein, M.M. Controlled Carbonation of Ca (OH) 2 Surface and Its Application as an Antibacterial Particle. Colloids Surf. A Physicochem. Eng. Asp. 2024, 682, 132852. [Google Scholar] [CrossRef]
- Jannah, Z.; Mubarok, H.; Syamsiyah, F.; H Putri, A.A.; Rohmawati, L. Preparation of Calcium Carbonate (from Shellfish)/Magnesium Oxide Composites as an Antibacterial Agent. IOP Conf. Ser. Mater. Sci. Eng. 2018, 367, 012005. [Google Scholar] [CrossRef]
- Rajagopal, M.; Walker, S. Envelope Structures of Gram-Positive Bacteria. In Protein and Sugar Export and Assembly in Gram-Positive Bacteria; Springer: Berlin/Heidelberg, Germany, 2015; pp. 1–44. [Google Scholar]
- Jahan, F.; Chinni, S.V.; Samuggam, S.; Reddy, L.V.; Solayappan, M.; Su Yin, L. The Complex Mechanism of the Salmonella Typhi Biofilm Formation That Facilitates Pathogenicity: A Review. Int. J. Mol. Sci. 2022, 23, 6462. [Google Scholar] [CrossRef] [PubMed]
- Ravichandran, K.; Chidhambaram, N.; Gobalakrishnan, S. Copper and Graphene Activated ZnO Nanopowders for Enhanced Photocatalytic and Antibacterial Activities. J. Phys. Chem. Solids 2016, 93, 82–90. [Google Scholar] [CrossRef]
- Ravichandran, K.; Chidhambaram, N.; Arun, T.; Velmathi, S.; Gobalakrishnan, S. Realizing Cost-Effective ZnO:Sr Nanoparticles@graphene Nanospreads for Improved Photocatalytic and Antibacterial Activities. RSC Adv. 2016, 6, 67575–67585. [Google Scholar] [CrossRef]
- Hazarika, M.; Boruah, P.K.; Pal, M.; Das, M.R.; Tamuly, C. Synthesis of Pd-rGO Nanocomposite for the Evaluation of In Vitro Anticancer and Antidiabetic Activities. ChemistrySelect 2019, 4, 1244–1250. [Google Scholar] [CrossRef]
- Haritha, V.; Gowri, S.; Janarthanan, B.; Faiyazuddin, M.; Karthikeyan, C.; Sharmila, S. Biogenic Synthesis of Nickel Oxide Nanoparticles Using Averrhoa Bilimbi and Investigation of Its Antibacterial, Antidiabetic and Cytotoxic Properties. Inorg. Chem. Commun. 2022, 144, 109930. [Google Scholar] [CrossRef]
- UR, S.; CR, R.K.; MS, K.M.; Betageri, V.S.; MS, L.; Veerapur, R.; Lamraoui, G.; Al-Kheraif, A.A.; Elgorban, A.M.; Syed, A.; et al. Biogenic Synthesis of NiO Nanoparticles Using Areca Catechu Leaf Extract and Their Antidiabetic and Cytotoxic Effects. Molecules 2021, 26, 2448. [Google Scholar] [CrossRef]
- Dewanjee, S.; Chakraborty, P.; Mukherjee, B.; De Feo, V. Plant-Based Antidiabetic Nanoformulations: The Emerging Paradigm for Effective Therapy. Int. J. Mol. Sci. 2020, 21, 2217. [Google Scholar] [CrossRef]
- Puri, A.; Mohite, P.; Maitra, S.; Subramaniyan, V.; Kumarasamy, V.; Uti, D.E.; Sayed, A.A.; El-Demerdash, F.M.; Algahtani, M.; El-kott, A.F.; et al. From Nature to Nanotechnology: The Interplay of Traditional Medicine, Green Chemistry, and Biogenic Metallic Phytonanoparticles in Modern Healthcare Innovation and Sustainability. Biomed. Pharmacother. 2024, 170, 116083. [Google Scholar] [CrossRef]

| Elements | Peak BE | FWHM (eV) | Area (P) CP (eV) | Atomic % |
|---|---|---|---|---|
| C 1s | 285.9 | 1.48 | 169,657 | 11.51 |
| Ca 2p3 | 347.29 | 2.52 | 253,832.8 | 4.54 |
| O 1s | 531.32 | 4.37 | 2,030,659.34 | 56.91 |
| Ni 2p | 855.53 | 4.28 | 4,138,711.06 | 21.86 |
| Na 1s | 1072.32 | 2.55 | 224,719.31 | 3.13 |
| MIC Values in µg/mL | ||
|---|---|---|
| Samples | Salmonella typhi (µg/mL) | Bacillus subtilis (µg/mL) |
| CaO | 750 | 750 |
| NiO | 187.5 | 375 |
| CaO/NiO | 46.8 | 23.4 |
| Standard | 0.468 # | 0.234 * |
| Sample/Assay | DPPH (IC50, µg/mL) | SO (IC50, µg/mL) |
|---|---|---|
| CaO | 121.2 ± 0.6 | 79.8 ± 0.7 |
| NiO | 119.6 ± 1.9 | 194.2 ± 1.2 |
| CaO/NiO | 96.8 ± 0.4 | 91.8 ± 0.1 |
| Standard | 92.8 ± 1.4 * | 59.2 ± 0.1 # |
| Sample/Assay | α-Amylase (IC50, µg/mL) | α-Glucosidase (IC50, µg/mL) |
|---|---|---|
| CaO | 176.7 ± 0.6 | 81.7 ± 1.9 |
| NiO | 105.2 ± 3.4 | 151.2 ± 2.9 |
| CaO/NiO | 98.6 ± 0.7 | 81.9 ± 0.5 |
| Standard | 32.8 ± 0.4 # | 47.0 ± 0.8 # |
Disclaimer/Publisher’s Note: The statements, opinions and data contained in all publications are solely those of the individual author(s) and contributor(s) and not of MDPI and/or the editor(s). MDPI and/or the editor(s) disclaim responsibility for any injury to people or property resulting from any ideas, methods, instructions or products referred to in the content. |
© 2025 by the authors. Licensee MDPI, Basel, Switzerland. This article is an open access article distributed under the terms and conditions of the Creative Commons Attribution (CC BY) license (https://creativecommons.org/licenses/by/4.0/).
Share and Cite
Priyadharshini, S.; Ayyanar, M.; Krishnasamy, R.; Sundarraj, M.; Sandoval-Hevia, G.; Thirumurugan, A.; Chidhambaram, N. Sustainable Biogenic Synthesis of High-Performance CaO/NiO Nanocomposite for Antimicrobial, Antioxidant, and Antidiabetic Applications. Ceramics 2025, 8, 46. https://doi.org/10.3390/ceramics8020046
Priyadharshini S, Ayyanar M, Krishnasamy R, Sundarraj M, Sandoval-Hevia G, Thirumurugan A, Chidhambaram N. Sustainable Biogenic Synthesis of High-Performance CaO/NiO Nanocomposite for Antimicrobial, Antioxidant, and Antidiabetic Applications. Ceramics. 2025; 8(2):46. https://doi.org/10.3390/ceramics8020046
Chicago/Turabian StylePriyadharshini, Saravanan, Muniappan Ayyanar, Ravichandran Krishnasamy, Manimaran Sundarraj, Gabriela Sandoval-Hevia, Arun Thirumurugan, and Natarajan Chidhambaram. 2025. "Sustainable Biogenic Synthesis of High-Performance CaO/NiO Nanocomposite for Antimicrobial, Antioxidant, and Antidiabetic Applications" Ceramics 8, no. 2: 46. https://doi.org/10.3390/ceramics8020046
APA StylePriyadharshini, S., Ayyanar, M., Krishnasamy, R., Sundarraj, M., Sandoval-Hevia, G., Thirumurugan, A., & Chidhambaram, N. (2025). Sustainable Biogenic Synthesis of High-Performance CaO/NiO Nanocomposite for Antimicrobial, Antioxidant, and Antidiabetic Applications. Ceramics, 8(2), 46. https://doi.org/10.3390/ceramics8020046

